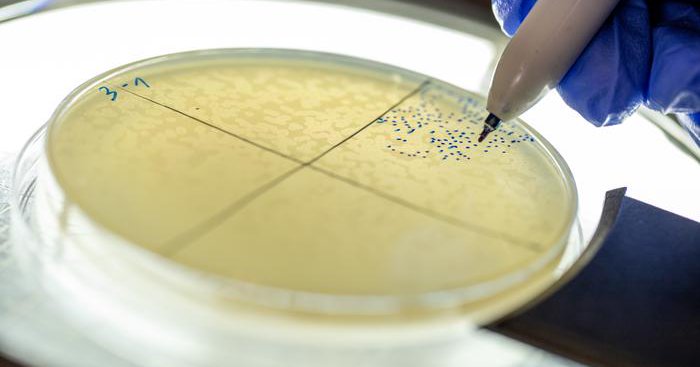
Tweet card summary image

Genetic Engineering & Biotechnology News
@GENbio
Followers
89K
Following
14K
Media
32K
Statuses
71K
Serving the biotech industry since 1981. EIC @johnsterling4; publisher @liebertpub Subscribe to GEN: https://t.co/KzqMccOt9Q
New Rochelle, NY
Joined April 2009
Viral sRNA Unlocks Phage Therapy Potential Against Drug-Resistant Bacteria Research revealed how #bacteriophages use a tiny piece of genetic material to hijack bacterial cells and make more copies of themselves @HebrewU
#phagetherapy #antibioticresistance
https://t.co/tPf8HJznsC
genengnews.com
Research revealed how bacteriophages use a tiny piece of genetic material to hijack bacterial cells and make more copies of themselves.
0
0
0
Engineered Dendritic Cells Harness Tumor EVs to Boost Cancer Immunotherapy Engineered dendritic cells capture tumor EVs, enhancing antigen presentation and T cell activation to boost #cancerimmunotherapy in preclinical models @EPFL_en
#EVs #dendriticcells
https://t.co/KmGHRTU1BY
genengnews.com
Engineered dendritic cells capture tumor EVs, enhancing antigen presentation and T cell activation to boost cancer immunotherapy in preclinical models.
0
2
2
Discover the MiSeq™ i100 Series: fast, accurate benchtop sequencing for all skill levels. Unlock same-day results for genomics research. Download the free eBook sponsored by @illumina: https://t.co/wd7Z1ZMxuh
#NGS #Genomics
0
0
3
Animal-Free Protein and Enzyme Deal Expanded by Dyadic and Fermbox Bio The agreement also allows both parties to incorporate products developed on #FermboxBio’s microbial platforms into the joint portfolio @DyadicInc
#enzymes #fermentation
https://t.co/o0hty8pbjP
genengnews.com
The agreement also allows both parties to incorporate products developed on Fermbox Bio’s microbial platforms into the joint portfolio.
0
0
4
Beyond Vaccines: Scaling the Promise of RNA Therapeutics From enzymes and lipid nanoparticles to large-scale process design, four global innovators redefine RNA-based medicine development and delivery #RNAtherapeutics #nanoparticles #drugdevelopment
https://t.co/csRvoBWE6l
genengnews.com
From enzymes and lipid nanoparticles to large-scale process design, four global innovators redefine RNA-based medicine development and delivery.
0
2
7
Brain’s Viral Defense Mechanism Linked to Tau Pathology in Alzheimer’s Data from a disease model showed that #HSV1infection caused tau hyperphosphorylation, forming aggregates that trapped viral capsids in place @MassGeneralNews
#Alzheimers #tau
https://t.co/niCA7WzQuN
genengnews.com
Data from a disease model showed that HSV1 infection caused tau hyperphosphorylation, forming aggregates that trapped viral capsids in place.
0
1
7
Gut Microbiome Shaped by Social Partners' Genes A study of over four thousand rats shows #gutmicrobiomes are shaped by both individual genes and the genes of social partners through shared microbes @CRGenomica
#genes #microbialinteraction
https://t.co/vStPvMWzF6
genengnews.com
A study of over four thousand rats shows gut microbiomes are shaped by both individual genes and the genes of social partners through shared microbes.
1
0
2
T Cell Populations in Aged Mice Rejuvenated by mRNA Delivery to Liver New data highlight liver-encoded delivery of immune modulators as a strategy to mitigate age-related #immunedysfunction
@zhangf
#Tcells #mRNA
https://t.co/QFyzJZ2ybX
genengnews.com
New data highlight liver-encoded delivery of immune modulators as a strategy to mitigate age-related immune dysfunction.
1
2
1
BASF Partners with Academia on Bioprocess Scale-Up PhD Program The companies, from multinationals to startups, will provide expertise and resources for the training program and offer students placements @BASF
#AI #biomanufacturing
https://t.co/vLnLbObICC
genengnews.com
The companies, from multinationals to startups, will provide expertise and resources for the training program and offer students placements.
0
1
6
Deep Learning Predicts Cell Behavior Dynamics in Early Drosophila Development Researchers suggest that MultiCell could potentially be used to discern early patterns of disease, such as in asthma @MITMechE @UMich
#cellbehavior #drosophila #deeplearning
https://t.co/wULUCq2zTJ
genengnews.com
Researchers suggest that MultiCell could potentially be used to discern early patterns of disease, such as in asthma.
0
0
3
Beyond Process Development: AI Reshaping Use of Digital Twins Artificial intelligence is changing how biopharma creates and uses digital models of manufacturing processes #AI #digitaltwins #biopharmaceuticals
https://t.co/ZAbqo7d5iL
genengnews.com
Artificial intelligence is changing how biopharma creates and uses digital models of manufacturing processes.
0
1
8
Colorectal Cancer Outcomes Explained by Distinct Regulatory T-Cell Subsets The results of the study could improve immunotherapy treatment for patients with colorectal and other barrier-tissue cancers @MSKCancerCenter
#immunotherapy #CRC #Tcells
https://t.co/0x70BFzRI3
genengnews.com
The results of the study could improve immunotherapy treatment for patients with colorectal and other barrier-tissue cancers.
0
1
4
At Noon (ET) today -- a live interview with Matthew Cobb on GEN Live >>>
Join me next Wednesday (noon ET) for a fun live interview with @matthewcobb -- author of the new biography "CRICK" https://t.co/9RJcmz67JV
0
2
3
Chai's the Limit for AI Antibody Designer After $130M Series B Funding Chai Discovery has completed a $130 million Series B financing that the AI-based antibody designer says will help it accelerate its research and product development #AI #antibodies
https://t.co/8l3o4iSmyX
genengnews.com
Chai Discovery has completed a $130 million Series B financing that the artificial intelligence (AI)-based antibody designer says will help it accelerate its research and product development, as well...
0
6
29
Discover the secrets behind DNA! Join GEN Live on Dec 17 with Matthew Cobb, PhD, author of "CRICK: A Mind in Motion." Register free: https://t.co/uNJUrgma7W
#MolecularBiology #Genetics #Science
0
0
6
Plant Hormone Controls Protein Levels in Living Worm, Improves Aging Model A new method uses the auxin-inducible degron (AID) system to tune protein levels with precision in living C. elegans @jeremyvicencio @CRGenomica
#aging #proteins #planthormones
https://t.co/sn7i0LV84S
genengnews.com
A new method uses the auxin-inducible degron (AID) system to tune protein levels with precision in living C. elegans.
1
2
5
Atelerix Inks Advanced Organoid Model Deal with Cherry Biotech The hydrogel preservation technology maintains #cellviability for days at room temperature, removing cold-chain constraints @AtelerixLtd @CherryBiotech
#organoids #hydrogeltechnology
https://t.co/JGSxeCh7qb
genengnews.com
The hydrogel preservation technology maintains cell viability for days at room temperature, removing cold-chain constraints.
0
1
5
Engineered mRNA System Delivers SMRTS for Cell-Selective Gene Expression SMRTS, a smart mRNA system, enables cell‑selective #geneexpression, expanding the mRNA toolbox for precision #cancertherapies
@MagdalenaZakPhD @LiorZangi @IcahnMountSinai
#mRNA
https://t.co/foASlovFeI
genengnews.com
SMRTS, a smart mRNA system, enables cell‑selective gene expression, expanding the mRNA toolbox for precision cancer therapies.
0
2
4
AI Tool Identifies Disease-Causing Genetic Mutations and Predicts Disease Type Investigations suggest V2P may be efficiently applied for the automated identification of causal #variants in sequencing data across #phenotypes
@IcahnMountSinai
#AI
https://t.co/IKVJx6Mhec
genengnews.com
Investigations suggest V2P may be efficiently applied for the automated identification of causal variants in simulated and actual patient sequencing data across phenotypes.
0
2
6
Fungal Vaccine Effort Gets $40 Million Federal Boost Candida vaccine will move through Phase I trials thanks to a $40 million competitive contract from NIH/NIAID @IbrahimLab3 @the_lundquist @VitalexBioscien
#fungalvaccine #Candida #clinicaltrials
https://t.co/Nq0Oo5JIb9
genengnews.com
Candida vaccine will move through Phase I trials thanks to a $40 million competitive contract from NIH/NIAID.
0
1
3